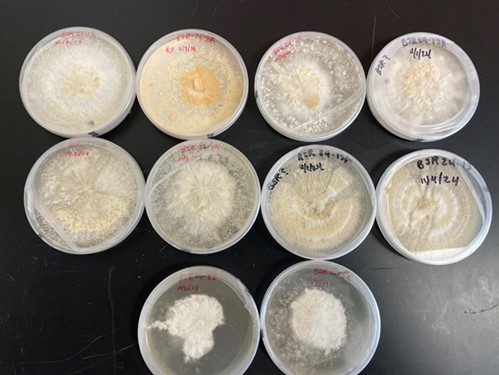
Cultures obtained from infected soybean samples exhibiting interveinal chlorosis in the treatment plots.

Accurate diagnosis of plant diseases and identification of their causative pathogens are essential for developing effective preventive measures. Evaluating seed treatments enables the identification of optimal management strategies before disease outbreaks become unmanageable, as demonstrated in the case of interveinal chlorosis and soybean cyst nematode (SCN) infection in North Dakota. To identify the pathogen responsible for interveinal chlorosis, symptomatic soybean plants (Figure 1) were collected throughout the trial period, and pathogens were isolated from various sections of the lower stems. Confirmation of the pathogen responsible for Brown Stem Rot (BSR) involved placing stem and pith slices on potato dextrose agar (PDA) and purifying on lima bean agar. To evaluate seed treatment chemicals for managing interveinal chlorosis, ILeVO, Saltro, Trunemco, Dynasty, Intego Solo, Trilex, and Rancona Summit were rigorously tested for their efficacy in suppressing both SCN and interveinal chlorosis, as well as leaf necrosis, under field conditions. The soybean variety 'ND21008GT20' was used in the study at the Langdon Research Extension Center (LREC) in Langdon, ND, in a field with a pH of 6.4 and an organic matter content of 1.6%. The previous crop was soybean, which was vertically tilled prior to planting, and the field had a documented history of interveinal chlorosis and SCN.
Figure 1: Leaves of soybean plants exhibiting interveinal chlorosis in the treatment plots.
Results
Morphological analysis revealed that ninety percent of the cultures matched Phialophora gregata, the causal agent of BSR (Figure 2). Concurrently, soil samples were randomly collected from the research area and analyzed at the AGVISE laboratory in Benson, MN, revealing an SCN population of 9,650 eggs per 100 cc of soil. Among the seed treatments, Trunemco, Dynasty, ILeVO, Rancona Summit, Intego Solo, and Saltro exhibited the lowest Normalized Disease Index, calculated based on interveinal chlorosis symptoms and severity obtained in the treatments. These results were statistically significantly different from those of the Trilex and untreated control treatments, highlighting their effectiveness in disease management and providing a foundation for further research and application (Table 1). Dissemination of these findings to growers and stakeholders will be facilitated through outreach activities across North Dakota.
Figure 2: Cultures obtained from infected soybean samples exhibiting interveinal chlorosis in the treatment plots.
Table 1: The seed treatments tested, their rates, and influence on the variables tested (Plant Stand, Plant Vigor, NDI, Yield, and Test Weight).
| Treatments | Plant Stand/A | Plant Vigor | NDI** | Yield (bu/A) | Test Weight (lbs/bu) |
| Ilevo | 119,184 | 7 | 11 | 43 | 57 |
| Saltro | 127,028 | 8 | 14 | 38 | 57 |
| Trunemco | 121,799 | 6 | 13 | 40 | 57 |
| Evergol Enegy | 120,274 | 7 | 6 | 47 | 57 |
| Non-Treated | 123,760 | 8 | 43 | 40 | 57 |
| Intego Solo | 128,554 | 8 | 19 | 45 | 57 |
| Rancona Summit | 138,577 | 8 | 19 | 44 | 57 |
| Trilex | 118,313 | 7 | 11 | 43 | 57 |
Mean | 124,686 | 7 | 17 | 42 | 57 |
CV % | 11 | 11 | 51 | 22 | 0.8 |
LSD | NS | 1 | 13 | NS | NS |
P-Value (0.5) | NS | 0.0105* | 0.0003* | NS | NS |
* Indicates the treatments have significant differences at P-Value < 0.05
** NDI: Normalized Disease Index: 0-100 scale incidence*severity/9
NS: Indicates the treatments have non-significant differences at P-Value < 0.05
Acknowledgements: Funding from North Dakota Soybean Council. Special thanks to Noah Foster, Kaleb Foster, Aiden Brown, and Carleen Schill.